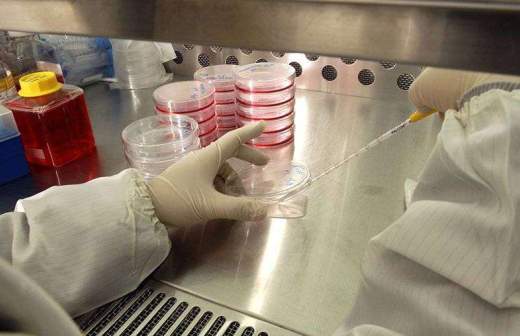

Прокурор Токио уходит в отставку из-за игры в маджонг во время режима ЧС

Руководитель токийской прокуратуры Хирому Курокава подал в отставку после скандала с игрой в азартные игры на деньги в период действия режима ЧС, который был введен из-за пандемии коронавируса. Об этом в четверг сообщил телеканал NHK.
Сообщается, что в мае Курокава несколько раз посещал квартиру журналиста газеты Sankei в Токио, где они играли в маджонг на деньги. В игре также участвовал корреспондент газеты Asahi. Передвигался прокурор на арендованной машине.
Поведение прокурора вызвало шквал критики со стороны общественности и оппозиционных партий. Особое недовольство вызвал тот факт, что 63-летний Курокава имеет близкие связи с премьер-министром Японии Синдзо Абэ.
Курокава сохранил должность прокурора Токио, несмотря на то что, согласно японскому законодательству, в этом возрасте необходимо оставить свой пост. Это могло быть связано с тем, что летом в Японии должен был смениться генеральный прокурор и Курокава был главным кандидатом на освобождающееся место, отмечает газета Mainichi.
14 мая правительство Японии объявило о снятии чрезвычайной ситуации, введенной из-за коронавируса, в большинстве префектур страны. Решение коснется 39 из 47 японских префектур. Режим ЧС сохраняется в Хоккайдо, Токио и прилегающих областях Чиба, Канагава и Саитама, а также в Осаке и Хиого.
Ранее сохранять режим ЧС по всей Японии планировалось до конца месяца.
11 мая министр здравоохранения, труда и благосостояния Японии Кацунобу Като заявил, что власти страны обнаружили на территории государства 250 очагов заражения коронавирусом. Большинство из них находится на территориях медицинских учреждений.
По данным статистического бюро Worldometer, на 20 мая в Японии 16 367 заболевших, 11 564 выздоровевших и 768 смертей от коронавируса.